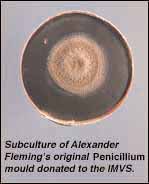

The Institute of Medical and Veterinary Science
Brendon J Kearney
Situated in the grounds of South Australia's principal teaching hospital, the IMVS provides a unique blend of statewide pathology services with comprehensive basic and clinical research programs.
MJA 1997; 167: 614-617
Introduction - Growth of the IMVS - Core pathology services - Research at IMVS - The Hanson Centre for Cancer Research - The future of IMVS - References - Authors' details
-
-
-
©MJA1997
Introduction | The Institute of Medical and Veterinary Science (IMVS), in Adelaide, South Australia, began in 1938 as a development from the Royal Adelaide Hospital (RAH) laboratories largely because Sir Trent Champion de Crespigny, an eminent physician, Medical Superintendent of the RAH and Dean of Medicine from 1929 to 1947, had a vision for an institute which combined laboratory services, teaching and research.1,2 In this respect, the IMVS differs from pure research institutes and has continued to emphasise an integration of service, teaching and research in clinical medicine. |
Growth of the IMVS |
The steady development of the IMVS was interrupted in the late 1970s by
a series of enquiries into management efficiency, services provided
and internal policies, as well as a critical review of the care and
control of animals used in scientific experiments. The result was a
major redefinition of core services: the Division of Forensic
Pathology and the Division of Biology became the Forensic Science
Centre (and relocated elsewhere in Adelaide) and the Division of
Veterinary Pathology was transferred to the South Australian
Department of Agriculture.
In July 1982, a new Act (with a new Council) defined and strengthened the relationships of the IMVS with the RAH and the University of Adelaide, allowing it to concentrate on the mainstream areas of medical pathology and their application to research, teaching and service. In 1986, an internal report (Review of Research) on the IMVS/RAH campus by Professors David Penington and Gustav Fraenkel outlined a framework for the development of research. The integration of service, teaching and research with the outcome of high quality care provided by clinicians actively engaged in research was endorsed in the report, but they also suggested the creation of separate basic science laboratories to support research and avoid disparate but duplicated facilities on the campus. They recommended that this development should be part of the IMVS/RAH campus because the benefits of a separate research centre would be diminished by the separation of research activities from service functions. The IMVS and RAH accepted the challenge, and by 1990 funds had been raised and the Hanson Centre (now the Hanson Centre for Cancer Research) had been established. Over the past decade, the IMVS has organised itself along business lines and become reliant on its ability to provide high quality patient services, attract grants and contract for service and research. About 80% of its $55 million expenditure annually is derived from contracts or grants (for public and private pathology services on a fee-for-service basis); the remaining 20% is derived from direct grants from the South Australian Government for statewide or specific pathology services. Therefore, the IMVS differs from pure research institutes that rely on government grants, research grants and donations. While this adds a complexity to its management, it is also a strength, ensuring that the IMVS remains competitive, efficient and relevant to the services for which it contracts. The strength of the IMVS is its collocation on the RAH and University of Adelaide medical school campus. This allows easy collaboration, integration and coordination with both the hospital and University, which has a symbiotic effect on achievement. This integration between hospital, university, service and research is exemplified by the organisational structure of the IMVS. |
Core pathology services |
The provision of a high quality general medical pathology service to
the RAH remains the core service of the IMVS, and The Queen Elizabeth
Hospital laboratories recently joined the IMVS. The IMVS also
provides pathology services to metropolitan and rural areas in South
Australia through a network of 12 country and regional laboratories.
These comprehensive, regionally based laboratory facilities have
ensured that a high quality pathology service is available to most
communities in South Australia. In addition, services are provided
to the Northern Territory and some areas in Victoria.
The integration of the IMVS with a teaching hospital and university medical school has allowed the IMVS to develop a comprehensive teaching and training program in pathology and to become involved in education and training in collaboration with clinical disciplines. |
Research at IMVS |
Examples of the symbiotic relationship between pathology services,
clinical services and research are illustrated by the research
endeavours occurring within the Divisions of the IMVS.
Division of Tissue PathologyThe Division of Tissue Pathology, developed by Professor Barrie Vernon-Roberts, is one of the largest in Australia, with specialists in tissue pathology subspecialising and with the Division integrated into the University of Adelaide and RAH.The Adelaide Head Injury Group incorporates neuropathology from the IMVS, neurosurgery from the RAH and bio mechanical engineering from the University of Adelaide's Road Accident Research Unit. Together, they form a unique combination collaborating in basic laboratory and clinical research into the effects of head injury caused by road trauma. The research objective of the Adelaide Head Injury Group is to reduce the severity of brain injury from accidents by prevention and early intervention. Until recently, brain injury was believed to be instantaneous and irreversible. Work undertaken by the group suggests that axonal damage evolves over hours and may be modified by early interventions. They have developed techniques to identify the pathological changes occurring within an hour of a head injury. The increased production of an amyloid precursor protein is a sensitive indicator of brain injury and can be used to measure the effectiveness of treatments aimed at reducing axonal damage. The Spinal Research Group has won several national and international awards, including the prestigious Volvo Prize (twice), the International Society for Biomechanics Prize, the Amrad Award, and the Smith and Nephew Spine Research Award (twice). It is supported by the specialised bone and histoquantification laboratories of Dr Robert Moore and Dr Nicola Fazzalari. The group collaborates closely with the RAH Spinal Services and RAH Department of Orthopaedics and Trauma. They used a sheep model to reproduce the pathology of human disc lesions and showed how investigational studies of discs can inadvertently introduce bacteria, causing damage to the disc and adjacent bone,3 and the beneficial effect of prophylactic antibiotics to prevent this common complication.4 Other studies have analysed the damage to the disc resulting from cumulative wear and tear to the spine, and have defined the biomechanical and biochemical characteristics of this degeneration. The researchers are currently examining the vascularisation of the disc during ageing, the potential for allograft disc replacement, and the use of cultured osteogenic precursor cells in surgical fusion of the spine. The Bone and Joint Group, in collaboration with the RAH Department of Orthopaedics and Trauma, studies bone structure and remodelling, with an emphasis on osteoarthritis and osteoporosis, using computerised analysis and modelling.5 The findings are relevant to development of preventive treatment for osteoporotic fractures and osteoarthritis.6 The group has also shown that loosening of artificial joints is caused by particles of metal or plastic released from the articulating surfaces.7 Division of Medical Microbiology and Virology
This Division is the core of the South Australian Infectious Diseases Service. It provides statewide services in food and environmental testing, monitoring of viral diseases and food- borne microbial diseases as well as the State HIV/AIDS Reference Laboratory and national Salmonella Reference Laboratory. A first for the microbiology laboratories was recognition of the association between commercial potting soils and Legionella longbeachae infections.9 They have played a leading role in developing diagnostic procedures for Legionella spp., as well as researching virulence mechanisms and their source and role in infections in the community. The expertise of the Division in applying research into service was shown during the 1995 outbreak of haemolytic- uraemic syndrome in South Australia.10 Three days after receipt of the first specimen, the laboratories had implemented a gene amplification test to detect toxin in food and clinical specimens, identified the toxigenic Escherichia coli strain and traced its source. The tracing of the source of E. coli within days contrasts to the weeks and months needed in outbreaks in Japan and the United States and was significant in rapidly controlling its spread. Infectious diseases research programs. The Division also maintains programs of basic research related to infectious diseases, largely funded by the National Health and Medical Research Council.
Adelaide Infectious Diseases Centre. The Division of Medical Microbiology and Virology provides a continuum from patient diagnostic testing, reference test development and public health to basic research. To maximise synergy between these activities, the Adelaide Infectious Diseases Centre has been established, combining the IMVS Division of Medical Microbiology and Virology, the University of Adelaide Department of Microbiology and the infectious diseases services of the RAH and The Queen Elizabeth Hospital. This group is pre-eminent in South Australia in infectious disease surveillance, reference testing, epidemiological studies and disease outbreak investigation. Division of Clinical BiochemistryBone research group. Professor Christopher Nordin, Associate Professor Allan Need and Associate Professor Howard Morris are addressing bone loss at the menopause, which, together with age-related bone loss, eventually leads to osteoporosis. Studies have established that increased urinary calcium excretion at menopause contributes significantly to bone loss.13 Increased dietary protein and salt exacerbate the urinary calcium "leak" and its effect on bone loss, while dietary restriction of these helps stabilise bone loss. Studies are being undertaken into the changes in the intestinal absorption of dietary calcium at menopause.14Studies on new therapies for osteoporosis and on the most effective way of monitoring treatment are continuing. A longitudinal study of osteoporosis in men has found that bone loss commences at age 50 and that the pattern and causes of bone loss are different from those found in women.15 The effects of diet, physical activity, hormone and growth factor levels are being evaluated for their effect on the rate of bone loss. A sophisticated rat model of postmenopausal osteoporosis has allowed investigation of the influences on bone at the molecular level. Local factors have been identified which protect bone from the increased cellular activity induced by oestrogen deficiency.16 The Detectacol bowel screening program was one of the earliest Australian voluntary bowel screening programs using an immunologically based test to detect faecal occult blood.17 It has been running for 15 years and has been endorsed through randomised controlled trials showing a reduction in mortality from colorectal cancer as a result of such screening techniques.18 Bone metastasis research. In collaboration with the Department of Surgery of the University of Adelaide, the Division is using a rat tumour model to study how metastatic tumours develop at incision sites after laparoscopic surgery. They will investigate changes in the immune state of the peritoneum and the effect of the different gases used to expand the peritoneum during laparoscopy. Division of HaematologyBone marrow transplantation. Haemopoiesis research began in the early 1980s, led by Dr Chris Juttner and Dr Bik To. They pioneered blood stem cell mobilisation and transplantation, which has now almost replaced autologous bone marrow transplantation.19 The group is currently seeking to define the role of integrin and bone resorption in mobilisation. Work continues on using haemopoietic stem cells purified using immunomagnetic techniques to refine the application in allogeneic and autologous transplantation in leukaemia, lymphoma and myeloma. Ex-vivo expansion is another project for which the Division has a pioneering role as a way of improving the safety of transplantation.20Dr Tim Hughes is leading a study of chronic myeloid leukaemia and has established a SCID-NOD model for characterising leukaemic stem cells.21 The group is currently involved in 12 clinical trials in transplantation for leukaemia and lymphoma. Research continues into mesenchymal stem cell and cellular therapies, cell death differentiation and oncogenesis and cellular interactions. The stromal group, led by Dr Paul Simmons, has made a major contribution on STRO-1-positive marrow stromal cell percursor and its role in bone formation, haemopoietic regulation and cellular therapies using marrow stromal tissue. Dr Sharad Kumar's group is studying apo ptosis, including the role, activation and regulation of caspases, the function of homologue(s) of C elegans CED-4 and the identification of CED-4M. The group is studying how integrins may modulate cytokine response and function of tetraspan and GPI-linked molecules. |
The Hanson Centre for Cancer Research |
The RAH Board and the IMVS Council have strongly supported the development of the Hanson Centre. Through fundraising, the RAH has provided $7.5 million over the past decade for the construction of buildings and provision of equipment for the Centre. The IMVS provides infrastructure funds from its operations and through its commercial company, Medvet Science Pty Ltd, created by the IMVS Council to commercialise the intellectual property and other biomedical activities of the IMVS/RAH campus, and has contributed in excess of $2 million in research grants and infrastructure funding to the Centre.
When the Centre began, in 1991, the core research groups were the RAH Division of Human Immunology and the Division of Haematology, but other groups have since joined, including the University of Adelaide Department of Cardiology and the RAH Departments of Gastroenterology, Rheumatology and Thoracic Medicine. These groups have their research support within the Hanson Centre, but are integrated into the service and teaching activities of the IMVS, RAH and the University of Adelaide. Professor Mathew Vadas, appointed 10 years ago to head the Division of Human Immunology, has developed strong basic research groups of excellence which have become known as the Hanson Centre for Cancer Research. This Centre is now the jewel in the research crown of the IMVS. Professor Vadas's research is focused on vascular biology.22,23 Other groups, led by Dr Shannon and Dr Cockerill, have had success in gene regulation,24 and Dr Gonda's laboratory is working on oncogene research.25 The Lipid Research Laboratory has succeeded in understanding the structural principles that govern the assembly of high density lipoprotein.26,27 It was known from epidemiological studies that the human blood high density lipoprotein fraction was protective against atherosclerosis, but the structural and functional basis for this protection was largely unknown. In collaboration with the Vascular Biology Laboratory, they discovered a novel and likely vital function for this particle that directly regulates the function of the vessel wall, and hence the propensity for atherosclerosis.23 Significant progress has been made in understanding cell death. The orderly and timely death of cells is essential in giving shape to the body and renewing its worn parts. A disorder in this process leads to abnormal growth that is a component of cancer. Work in the Molecular Regulation Laboratory, headed by Dr Sharad Kumar, and the Cytokine Laboratory of Dr Angel Lopez has provided novel insights into this process.28 The signals that are involved in "sentencing" and "execution" leading to cell death have been elaborated, and a new therapeutic agent based on an actual growth factor has been discovered that induces this process in blood cells. It is likely that the clinical implications of these discoveries will be considerable. |
The future of IMVS | The IMVS will maintain a business-like approach to the management of operations and to the continued development of Medvet Science. A recent external review of research on the IMVS/RAH/University of Adelaide campus, led by Professor Lawrie Powell, has commented on the excellent productivity of research on the campus. The IMVS intends to further enhance research through expansion of laboratories for basic research while maintaining the strong integration of teaching, patient services and clinical research. New areas of research are being developed in the neurosciences and in molecular pathology, with an emphasis on cancer genetics. |
References |
|
Authors' details
The Institute of Medical and Veterinary Science, Adelaide, SA.Brendan J Kearney, FRACP, FRACMA, Director.
Reprints: Professor B J Kearney, Director, Institute of Medical and Veterinary Science, PO Box 14, Rundle Mall, SA 5000.
- ©MJA 1997
Readers may print a single copy for personal use. No further reproduction or distribution of the articles should proceed without the permission of the publisher. For permission, contact the Australasian Medical Publishing Company
Journalists are welcome to write news stories based on what they read here, but should acknowledge their source as "an article published on the Internet by The Medical Journal of Australia <http://www.mja.com.au>".
<URL: http://www.mja.com.au/> © 1997 Medical Journal of Australia.
Received 22 November 2025, accepted 22 November 2025
- Brendon J Kearney

The Division of Medical Microbiology and Virology has a long and
distinguished reputation. Dr J E McCartney, Medical Bacteriologist
at the IMVS in the early 1950s, was a close colleague of Alexander
Fleming (the discoverer of penicillin), who gave him some of the
original Penicillium mould. Professor Barrie
Marmion, Professor of Virology at the IMVS during the 1980s, worked on
developing an effective Q fever vaccine and on hepatitis B. Professor
Christopher Burrell, the current Head, is acclaimed for his cloning
of the hepatitis B genome.
The Division of Medical Microbiology and Virology has a long and
distinguished reputation. Dr J E McCartney, Medical Bacteriologist
at the IMVS in the early 1950s, was a close colleague of Alexander
Fleming (the discoverer of penicillin), who gave him some of the
original Penicillium mould. Professor Barrie
Marmion, Professor of Virology at the IMVS during the 1980s, worked on
developing an effective Q fever vaccine and on hepatitis B. Professor
Christopher Burrell, the current Head, is acclaimed for his cloning
of the hepatitis B genome.